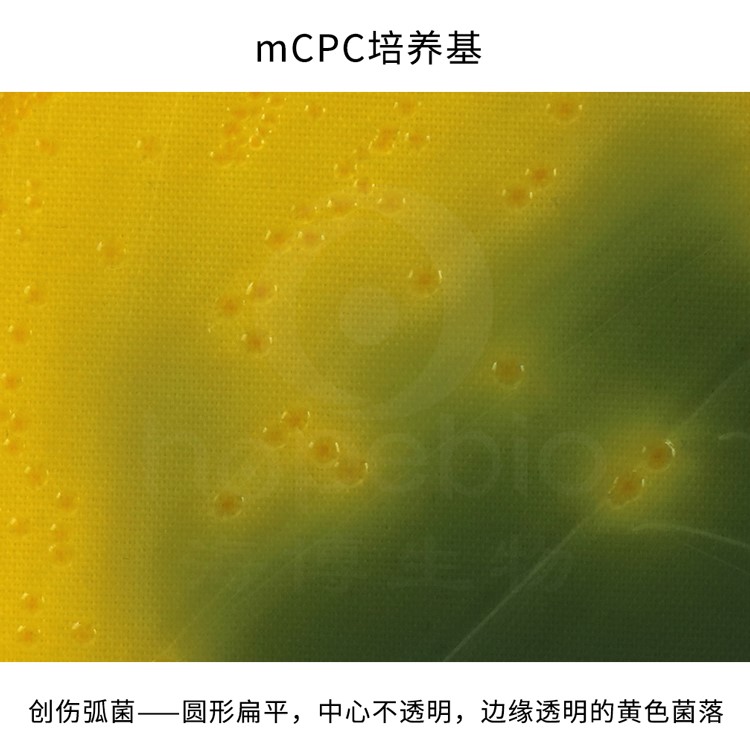

海博微信公众号
海博微信公众号
 海博天猫旗舰店
海博天猫旗舰店


 海博微信公众号
海博微信公众号
 海博天猫旗舰店
海博天猫旗舰店




海洋覆盖了地球表面的71%,是地球上最大的生态系统。在这片蔚蓝的疆域中,除了肉眼可见的鱼群、珊瑚和藻类,还隐藏着一个肉眼不可见的微观世界——数以亿计的微生物构成了海洋生态系统的基石。它们不仅驱动着地球的物质循环,还影响着气候、碳汇甚至人类生活。以下将从不同类群出发,揭开海洋微生物的神秘面纱。
一、浮游植物:海洋的“绿色引擎”
作为海洋初级生产力的核心,浮游植物通过光合作用固定二氧化碳,为整个海洋食物链提供能量。
1. 蓝藻(Cyanobacteria)
蓝藻是地球上最古老的光合生物之一。海洋中的聚球藻(Synechococcus)和原绿球藻(Prochlorococcus)是蓝藻的代表,后者甚至被称为“海洋中最高产的生物”,每升海水中可存在数百万个细胞。它们贡献了全球约20%的光合作用产氧量,堪称“看不见的森林”。我公司有用于蓝藻细菌培养的BG11培养基,详情请见表1。
2. 硅藻(Diatoms)
硅藻以其精美的硅质外壳著称,是极地和高营养海域的主要生产者。例如中肋骨条藻(Skeletonema)在春季会爆发性增殖,形成“藻华”,为鱼类提供丰富的饵料。
3. 甲藻(Dinoflagellates)
甲藻中的夜光藻(Noctiluca scintillans)能产生生物荧光,形成“蓝眼泪”奇观;而某些种类如短凯伦藻(Karenia brevis)则会释放毒素,引发赤潮,导致鱼类大规模死亡。
二、细菌与古菌:物质循环的“幕后推手”
海洋中90%以上的有机碳分解依赖于微生物,其中细菌和古菌功不可没。
1. SAR11菌群
隶属于α-变形菌纲的SAR11是海洋中数量最多的细菌类群,占表层海水微生物总量的25%~40%。它们擅长在寡营养环境中生存,通过分解溶解态有机物维持碳循环。
2. 趋磁细菌(Magnetotactic
Bacteria)
趋磁细菌是一类在外磁场的作用下能作定向运动并在体内形成纳米磁性颗粒-磁小体(Magnetosome)的细菌。海洋沉积物中的趋磁球菌(Magnetococcus)通过氧化硫化物获取能量,同时参与铁、硫元素的生物地球化学循环。
3. 古菌(Archaea)
海洋中的古菌种类繁多,如广古菌门中的产甲烷菌、极端嗜盐菌在海洋沉积物和深海环境中广泛分布,参与碳循环和甲烷代谢;泉古菌门多生活在极端环境中,如深海热液喷口;奇古菌门则广泛分布于海洋中,尤其是氨氧化古菌主导海洋氮循环,将氨转化为亚硝酸盐,避免氨积累造成的生态毒性。
三、真菌与病毒:生态系统的“调控者”
1. 海洋真菌(Marine Fungi)
腐生真菌如木霉(Trichoderma)负责降解海洋中的木质纤维素,而寄生性真菌如海壶菌(Haliphthoros)会感染甲壳类动物,调控种群平衡。近年发现的深海真菌聚多曲霉(Aspergillus sydowii)甚至能分解原油污染物。
2. 海洋病毒(Marine
Viruses)
每升海水中含有约100亿个病毒颗粒,其中噬菌体(如感染蓝藻的噬藻体)每天可杀死约20%的海洋细菌,释放的有机物相当于全球人类呼吸量的10倍。巨型病毒如米米病毒(Mimivirus)甚至能感染原生生物,重塑微生物群落结构。此外,病毒通过水平基因转移加速了宿主进化,例如某些藻类的光合作用基因可能源自病毒。我公司有噬菌体培养基相关产品,详情请见表1。
四、微生物与人类:从威胁到机遇
海洋微生物对人类的影响复杂而深远:
1. 威胁:霍乱弧菌(Vibrio cholerae)(如图1)是人类霍乱的病原体,通过贝类传播引发疾病,霍乱是一种古老且流行广泛的烈性传染病之一,曾在世界上引起多次大流行,主要表现为剧烈的呕吐、腹泻、失水,死亡率甚高,我公司有霍乱弧菌相关产品,详情请见表1;甲藻产生的石房蛤毒素可沿食物链富集,导致人类中毒;创伤弧菌(Vibrio vulnificus)(如图2)是一种主要存在于温暖海水或海鲜中的致病性细菌,可通过伤口接触海水、被海产品划伤、食用未煮熟的海鲜等途径感染人体,感染后可能引发败血症、坏死性筋膜炎等严重并发症,尤其对免疫力低下、慢性肝病或糖尿病患者威胁极大。我公司有用于弧菌显色培养的弧菌显色培养基(第二代)和弧菌显色培养基平板(9cm),详情请见表1。

图1 四号琼脂平板上的非01群霍乱弧菌
图2 mCPC培养基上的创伤弧菌
创伤弧菌呈圆形扁平、中心不透明、边缘透明的黄色菌落
2. 机遇:深海嗜压菌(如希瓦氏菌属Shewanella)的酶类可用于生物燃料生产;珊瑚共生菌(如共生藻属Symbiodinium)的研究为珊瑚白化治理提供线索;从海绵共生微生物中提取的抗癌药物(如软海绵素)已进入临床试验。
五、结语:看不见的守护者
海洋微生物虽小,却是地球生命网络的“隐形工程师”。它们维系着海洋生态平衡,调控全球气候,甚至蕴藏着解决能源与医疗难题的钥匙。随着宏基因组学、单细胞测序等技术的发展,这片微观世界的奥秘正被逐步揭开——或许未来某天,人类文明的存续也将依赖于这些微小的生命体。
表1 青岛海博生物相关产品信息
|
产品编号 |
产品名称 |
规格 |
产品说明及用途 |
|
HB8793 |
250 g |
用于蓝藻细菌培养 |
|
|
HB7011-5 |
1000mL |
用于弧菌的显色培养 |
|
|
HBPM7011-1 |
9cm*10个/包 |
用于弧菌的显色培养 |
|
|
HB4129 |
250 g |
用于霍乱弧菌选择性增菌培养 |
|
|
HB4133-2 |
250g |
用于霍乱弧菌的分离培养(GB标准) |
|
|
HB4146 |
250g |
用于霍乱弧菌的培养(SN标准) |
|
|
HB4151-2 |
250g |
用于创伤弧菌分离 |
|
|
HB8852 |
250g |
用于创伤弧菌的分离培养 |
|
|
HBJZ085 |
支 |
主要用于阳性对照反应和培养基质量控制等实验 |
|
|
HB9174 |
250g |
用于创伤弧菌的选择性增菌培养 |
|
|
HB8780 |
250g |
用于大肠杆菌噬菌体MS2培养 |
|
|
HB9269 |
250g |
用于噬菌体宿主菌的增菌培养 |
注:本文属海博生物原创,未经允许不得转载。
上一篇:抗生素在培养基中的作用及其机制
下一篇:没有了!
| 相关文章: | ||



